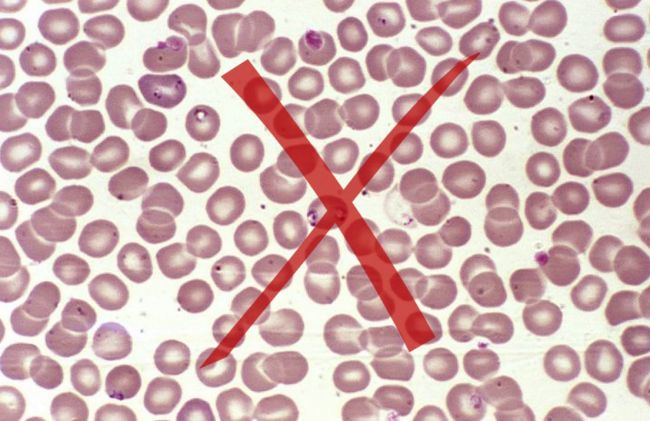
parasitos-tachados

Ya estamos atendiendo nuevamente comuniquese con nosotros por whatsapp al +51 - 973586834 para recibir nuestros tratamientos.
Conoce las propiedades y valor nutricional del achiote, una especie que cuenta con virtudes que van más allá de sus beneficios para saborizar y colorear tus comidas.
Enterate como el achiote puede reducir tu azúcar en sangre, cuidar tu visión, fortalecer tus huesos y aprende sus propiedades medicinales para retrasar el envejecimiento.
_optimized.jpg)
El achiote es una semilla que se utiliza generalmente como colorante en algunas preparaciones, pero muy poco se sabe de sus propiedades medicinales.
A su vez reduce el efecto de los radicales libres, con lo cual se le han atribuido propiedades anticancerígenas y antioxidantes.
En el estudio se ha evidenciado que su poder para inhibir la multiplicación de células cancerígenas es de un 87% gracias a la presencia de la norbixina la cual es un potente antioxidante del grupo de los carotenoides. (1)

Si eres una persona que sufre de diabetes el consumo de achiote te será de gran ayuda estudios realizados han encontrado que el extracto de estas semillas tienen propiedades hipoglucemiantes. Su uso resulta de utilidad para disminuir la glucosa en ayunas y posprandial al mejorar la utilización de la insulina.
El achiote aumenta las defensas que se encuentran debilitadas en personas con diabetes, reforzando su sistema antioxidante y previniendo las complicaciones de la diabetes. (2) (3).

Como sabemos la Histamina es una sustancia que el sistema inmunológico produce cuando un cuerpo o sustancia extraña ingresa a nuestro organismo, como ocurre en las alergias, y produce vasodilatación es decir aumenta la permeabilidad en las articulaciones y el dolor.
El achiote cuenta con actividades antiinflamatorias e inhiben la permeabilidad vascular, y controlan la alergia y también resulta útil para controlar la inflamación en enfermedades como la artritis. (4)

Estudios realizados en las dos últimas décadas ha demostrado que la aplicación de achiote como remedio casero disminuye de manera significativa los síntomas de Gonorrea, una enfermedad de transmisión sexual.
El achiote se ha identificado entre las 9 plantas con mayor poder para controlar los síntomas de la gonorrea y resulta una opción extra para el tratamiento dada la resistencia frecuente a los antibióticos. (5)

El achiote es una semilla rica en Bixina un carotenoide el cual está muy relacionados a la salud de nuestros ojos.
El empleo de achiote en la dieta se propone entonces como un remedio natural para prevenir y tratar de la degeneración macular, causa frecuente de reducción de la visión producto del envejecimiento.(6)

Las personas con fragilidad ósea como son las que padecen de Osteoporosis tienen un gran aliado en las semillas de achiote ya que su buen aporte de calcio y Tocotrienol (familia de la vitamina E).
De acuerdo a otro estudio el tocotrienol permite la recuperación y prevención de la osteoporosis, pérdida de masa ósea en mujeres posmenopáusicas. (7) (8)
El achiote es muy usado como un digestivo natural, aliviando los molestos dolores y ardor estomacal. A su vez también es utilizado en enfermedades estomacales relacionadas a parásitos gracias a los taninos contenidos en achiote los cuales tienen una función antimicrobiana y antifúngica.
Es eficaz para combatir la indigestión, diarrea, dolor abdominal al enfrentar microorganismos que pueden afectar al ser humano y aparato digestivo como Staphylococcus aureus, Salmonella typhi, Escherichia coli, Candida albicans llegando a ser similar su efecto a medicamentos utilizados contra virus y bacterias. (9)

Las semillas de achiote son ricas en antioxidantes las cuales le confieren propiedades regenerativas y desinflamatorias en heridas menores, como pueden ser cortes, ampollas de quemadura o ampollas simples.
Se observó en este estudio que la incorporación de achiote a los 7 días acelero la curación de heridas comparado con un grupo de animales sin tratamiento con una mayor rapidez en el restablecimiento del colágeno e inhibió la inflamación favoreciendo la cura de las heridas bucales. (10)

Según estudios realizados las semillas de achiote no son las únicas con propiedades medicinales sino también sus hojas. Pruebas realizadas en laboratorio comprobó que el extracto metanólico obtenido de las hojas de achiote es un eficaz antibacteriano ya que eliminó la propagación de bacterias peligrosas como de Staphylococcus aureus y Streptococcus faecalis.
A su vez brinda protección frente al mosquito Aedes aegiptii importante transmisor de enfermedades en el ser humano con una eficacia de entre el 20 y 90%. (11)
El maravilloso poder antienvejecimiento que nos brinda el achiote se le atribuye a un compuesto perteneciente a la familia de la vitamina E llamado Tocotrienol, un antioxidante, el cual nos protege de los daños en la piel ocasionados por el paso del tiempo, el efecto de los rayos UV y químicos como los medicamentos. A su vez tiene un papel regenerativo en todos los tejidos de nuestro organismo.
No se requieren grandes cantidades de achiote para disfrutar de sus beneficios y a las 8 horas los consumidores pueden eliminarlo del cuerpo sin efectos secundarios. (10)